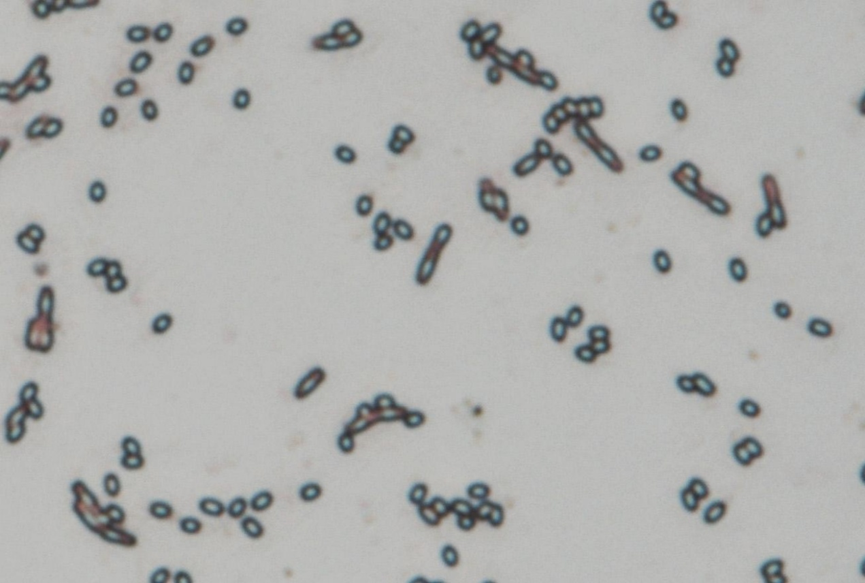

主播丨晓风Brisk
从专业视角拆解风险的底层逻辑
2001年,“9·11”阴影未散,一封封携带致命粉末的邮件让全美陷入二次恐慌。FBI追踪数年,最终将矛头指向美国最顶级的生物防御实验室——德特里克堡
风已起、等你来听
——
时间轴
00:35 如果恐惧有形状
02:50 炭疽杆菌孢子
06:56 德特里克堡
08:13 布鲁斯·艾文斯
10:22 “首因效应”和“沉锚效应”
——
致命邮件/ANTHRAX


信件上的文字


NBC、ABC、CBS,美国传统三大全国性商业广播电视公司
National Broadcasting Company 美国全国广播公司
American Broadcasting Company 美国广播公司
Columbia Broadcasting System 哥伦比亚广播公司
A类生物毒剂
炭疽芽孢杆菌、重型天花病毒、鼠疫耶尔森菌等,这些生物毒剂易在人间传播,对公众健康构成严重威胁,并可能引发社会恐慌
炭疽感染图片

炭疽杆菌图片

孢子/芽孢图片
细菌芽孢
整个生物界中抗逆性最强的生命体,在抗热,抗化学药物和抗辐射等方面十分突出
臭名昭著的德特里克堡

BSL-4实验室
生物安全等级最高的实验室,专门用于研究和操作地球上最危险、无有效治疗和预防手段的病原体
首因效应
个体在社会认知过程中,最先输入的信息对客体以后的认知产生的决定性影响
沉锚效应
人们在做判断时,会过度依赖最早获得的第一个信息(即“锚点”),即使这个信息与决策无关,后续的思考也会被这个“锚”牢牢固定,难以做出充分调整
——
人类毁灭指南丨CBRN系列丨B-1
Chemical化学、Biological生物、Radiological放射性、Nuclear核
——
片尾曲
夜的第七章-周杰伦&潘儿



 32
32 5
5


